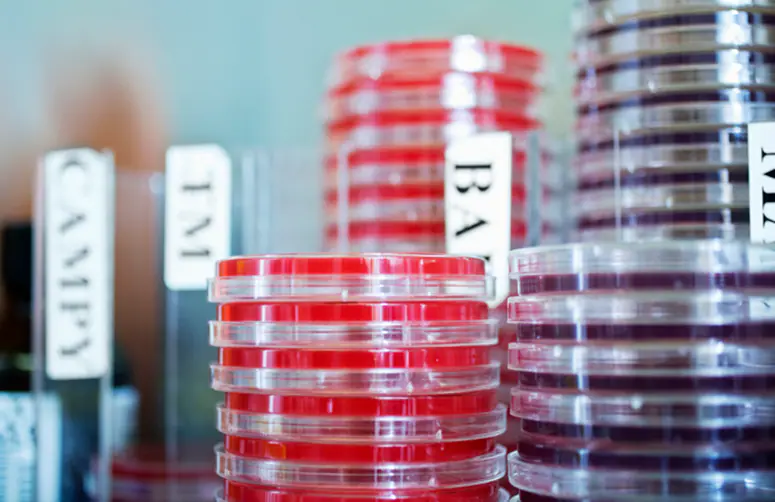
Stacks of Petri dishes – shallow lidded dishes with growth media in which cells can be cultured.

At a glance
To understand current laboratory methods, policies, and procedures and to monitor changes over time, FoodNet periodically surveys all clinical laboratories within the surveillance area.
Background
More than 700 clinical laboratories in the FoodNet surveillance area test specimens from ill people. These laboratories differ in their routine testing practices for foodborne pathogens and in methods they use. Such differences may contribute to variation in the incidence rate of reported infections between FoodNet sites.
To understand current practices and to monitor changes in practices over time, FoodNet conducts periodic surveys of all clinical laboratories within the surveillance area.
FoodNet conducted general surveys in 1995 (during the pilot phase of FoodNet surveillance), 1997, and 2000, and pathogen-specific surveys in 2005 and 2007. A brief summary of results and a list of associated publications are included below.
In 2010, FoodNet began to routinely survey clinical laboratories serving surveillance area residents on the use of new testing methods to detect enteric pathogens in stool specimens.
Surveys
In 1995, 1997, and 2000, FoodNet conducted surveys to describe laboratory methods and policies for the routine testing of stool specimens for Salmonella, Shigella, Campylobacter, Vibrio, Yersinia entercolitica, and E. coli O157:H7. Results showed that all or almost all laboratories routinely tested for Salmonella, Shigella, and Campylobacter, but only about half routinely tested for E. coli O157:H7, Yersinia entercolitica, or Vibrio spp. In 2000, FoodNet also queried labs about testing practices for parasitic agents. Most laboratories sent specimens off site for parasitic screening and did not routinely test fecal specimens for Cryptosporidium species or Cyclospora cayetanensis unless requested by a physician.
Please contact foodnet@cdc.gov to request a copy of the questionnaires and protocols.
References
In 2005, FoodNet conducted a survey to describe laboratory characteristics, stool specimen collection methods, transport methods and times, and culture and incubation procedures used to isolate and identify Campylobacter. Results showed that adherence to existing recommendations for isolation and identification of Campylobacter varied substantially between laboratories and that many were using techniques likely to reduce their ability to isolate Campylobacter.
Please contact foodnet@cdc.gov to request a copy of the questionnaire and protocol.
References
In 2007, FoodNet conducted a survey to describe culture-based and culture-independent testing practices for STEC identification. Results showed that most laboratories complied with recommendations for O157 STEC testing by culture but not with recommendations for detection of non-O157 STEC.
Please contact foodnet@cdc.gov to request a copy of the questionnaire and protocol.
